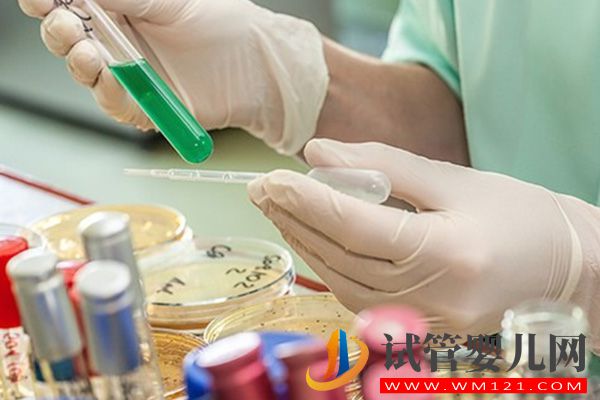
唐山市人民醫(yī)院試管嬰兒費(fèi)用預(yù)估(圖2)

唐山市人民醫(yī)院試管嬰兒費(fèi)用預(yù)估
唐山人民醫(yī)院,占地面積5萬(wàn)多平方米,編制床位1040張,擁有51個(gè)臨床科室,還擁有眾多先進(jìn)醫(yī)療設(shè)備,讓唐山百姓足不出市就能享受到國(guó)內(nèi)、國(guó)際一流的高端醫(yī)療水平。很多不了解情況的不孕不育患者,打算前往這家醫(yī)療機(jī)構(gòu)做試管嬰兒助孕,但目前來(lái)說(shuō)唐山人民醫(yī)院不具備衛(wèi)計(jì)委批準(zhǔn)開展輔助生殖技術(shù)資質(zhì),暫不能做試管嬰兒,如果有試管需求,可根據(jù)自身實(shí)際情況,選擇唐山市開展輔助生殖醫(yī)療的機(jī)構(gòu)就醫(yī)。

唐山人民醫(yī)院無(wú)試管資質(zhì)
2023唐山市人民醫(yī)院試管嬰兒費(fèi)用
目前在唐山人民醫(yī)院暫不能做試管嬰兒助孕,對(duì)于在唐山市內(nèi)的不孕不育患者來(lái)說(shuō),可以就近到唐山市婦幼就診。不管在哪個(gè)生殖醫(yī)院做試管,其流程步驟都可可分為進(jìn)周促排、取卵取精、胚胎培養(yǎng)、檢測(cè)與移植,為便于大家了解唐山試管嬰兒費(fèi)用情況,這里就有一份有關(guān)唐山試管嬰兒的費(fèi)用清單明細(xì):
1、術(shù)前檢查費(fèi)
雖然唐山人民醫(yī)院暫不能做試管嬰兒,但是可以在該院做術(shù)前檢查,通常在進(jìn)行試管嬰兒治療前,不孕不育夫婦雙方要進(jìn)行術(shù)前檢查,主要是排除一些不適合進(jìn)行試管嬰兒的疾病如傳染性疾病和不適合女方懷孕的疾病,女性術(shù)前檢查費(fèi)大約5000元左右,男性術(shù)前檢查花費(fèi)3000元左右。
試管藥費(fèi)大概在9千-1.5萬(wàn)元左右
2、試管嬰兒藥費(fèi)
試管嬰兒是通過(guò)藥物促排卵后取出女方的卵子,一般要使用20-40支促排卵激素藥物,在加上前面使用的降調(diào)節(jié)激素藥,總共需要大概9000-15000元左右。
3、胚胎移植費(fèi)
試管嬰兒的取卵、培養(yǎng)、移植等環(huán)節(jié)費(fèi)用,如果有多余優(yōu)質(zhì)胚胎要進(jìn)行冷凍保存,需要額外支付費(fèi)用,這部分花費(fèi)大約在10000元左右,如果需要進(jìn)行單精子注射(ICSI)要再加2000元左右。





